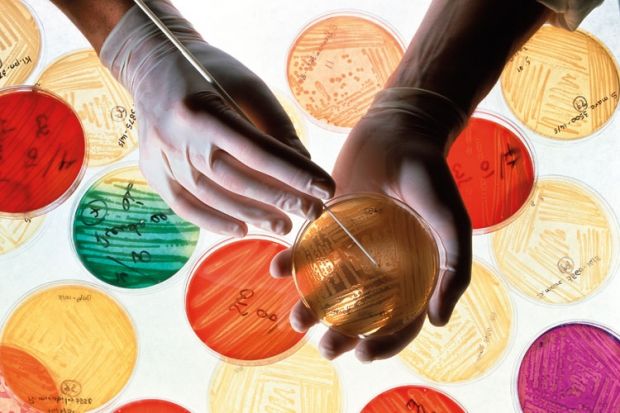

Source: Science Photo Library
Kaleidoscopic information: restrictions on the use of medical databases could halt a medical breakthrough, some fear
Hundreds of millions of pounds worth of research could be derailed by changes to data protection regulations proposed by a committee of the European Parliament, according to the head of one of the research councils.
The mooted amendments will “weaken” the UK’s leading position in medical informatics and potentially block a “revolution in medical research and care”, Sir John Savill, chief executive of the Medical Research Council, told Times Higher Education.
More than 40 research organisations, including four of the UK’s research councils and major charitable funders including the Wellcome Trust and Cancer Research UK, signed a petition in late January urging members of the European Parliament to oppose the changes.
The amendments, suggested by the European Parliament’s Committee on Civil Liberties, Justice and Home Affairs (LIBE) in October, would tighten the rules that protect people’s personal data. But Sir John said that large sums of money invested in medical informatics capability over the past decade “would be at threat”.
Beth Thompson, policy adviser at the Wellcome Trust, said investment and funding commitments worth £200 million could be affected, including the Farr Institute, a series of health informatics research centres linking 19 universities, and the UK Biobank.
Facilities such as the Biobank hold health and personal data on hundreds of thousands of people, who give broad consent for research when donating the information. But under LIBE’s proposals, specific consent would be required from each individual for every piece of research.
“The researchers would be spending lots of time and money contacting all the participants…repeatedly,” Sir John said.
He added that the suggested changes would “frustrate the altruistic intentions of around 2.5 million people in Britain alone who have signed up to participate in large cohort studies”.
“It would render the research that we have funded very difficult to do and in some cases illegal… This is a big concern,” Sir John said.
The changes would also affect research databases on wages, tax and pensions established by the Economic and Social Research Council, he said.
The University of Salford is among those that has signed the petition. Jo Cresswell, its associate director for research, said: “The value of data in health research is that you have this massive source of information which can then be mined as and when individual research questions come up.”
Dr Thompson said that the original draft regulations, issued by the European Commission in 2012, set out an exemption for research, but the amendments by LIBE “basically removed” these. Although LIBE has left a “tiny exemption”, it is not clear how that would work in practice and it does not apply to certain types of data, she added.
The European Council of Ministers has yet to give its position on the draft regulations. Once it has, the Council, the Parliament and the Commission will enter negotiations to create a final draft.
Register to continue
Why register?
- Registration is free and only takes a moment
- Once registered, you can read 3 articles a month
- Sign up for our newsletter
Subscribe
Or subscribe for unlimited access to:
- Unlimited access to news, views, insights & reviews
- Digital editions
- Digital access to THE’s university and college rankings analysis
Already registered or a current subscriber?